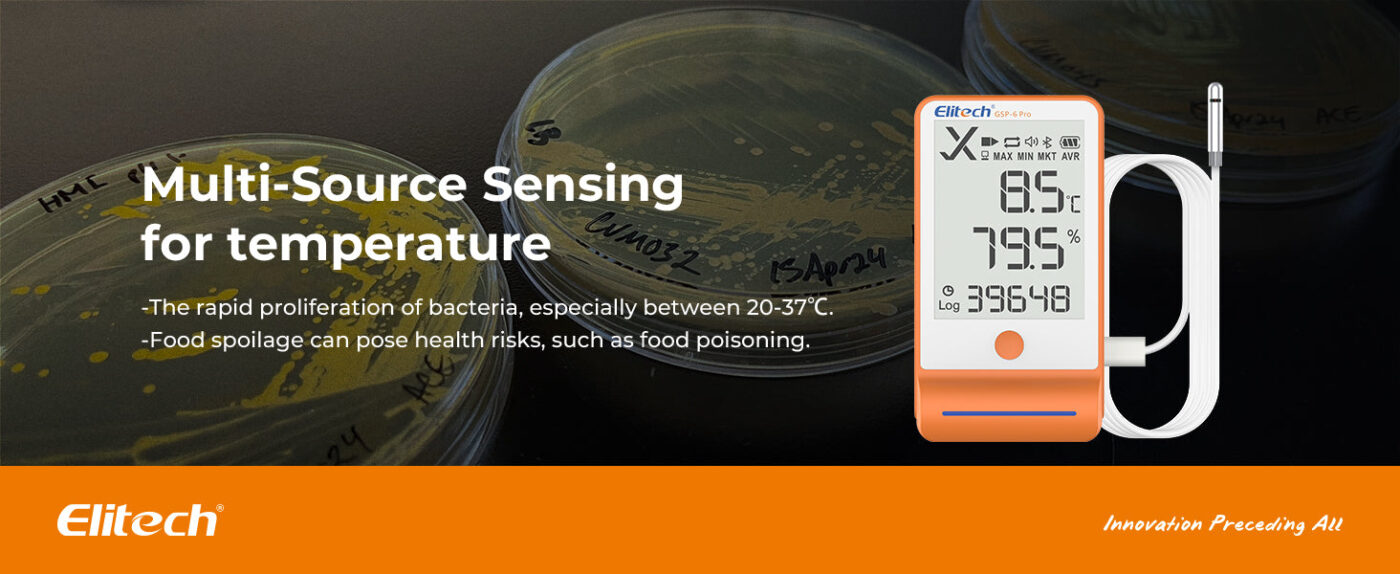

Digital Temperature And Humidity Data Logger Detachable Dual Probes
₱ 0.00
Product ID: GSP-6Pro
Brand: Elitech -China
Elitech Bluetooth Hygrometer Thermometer Data Logger Temperature Humidity with Shadow Data 100000 Points Data Storage Export, Pharmacy Vaccine DDL Calibration Certificate, MAX MIN AVR MKT
Certified by:
NOTE: No Exchange No Return Learn More
Warranty: 1 year from the delivery date, covers manufacturing defects, if any. It does not cover breakage or misuse.
Quality comes first and our products are designed to last.
Available on backorder